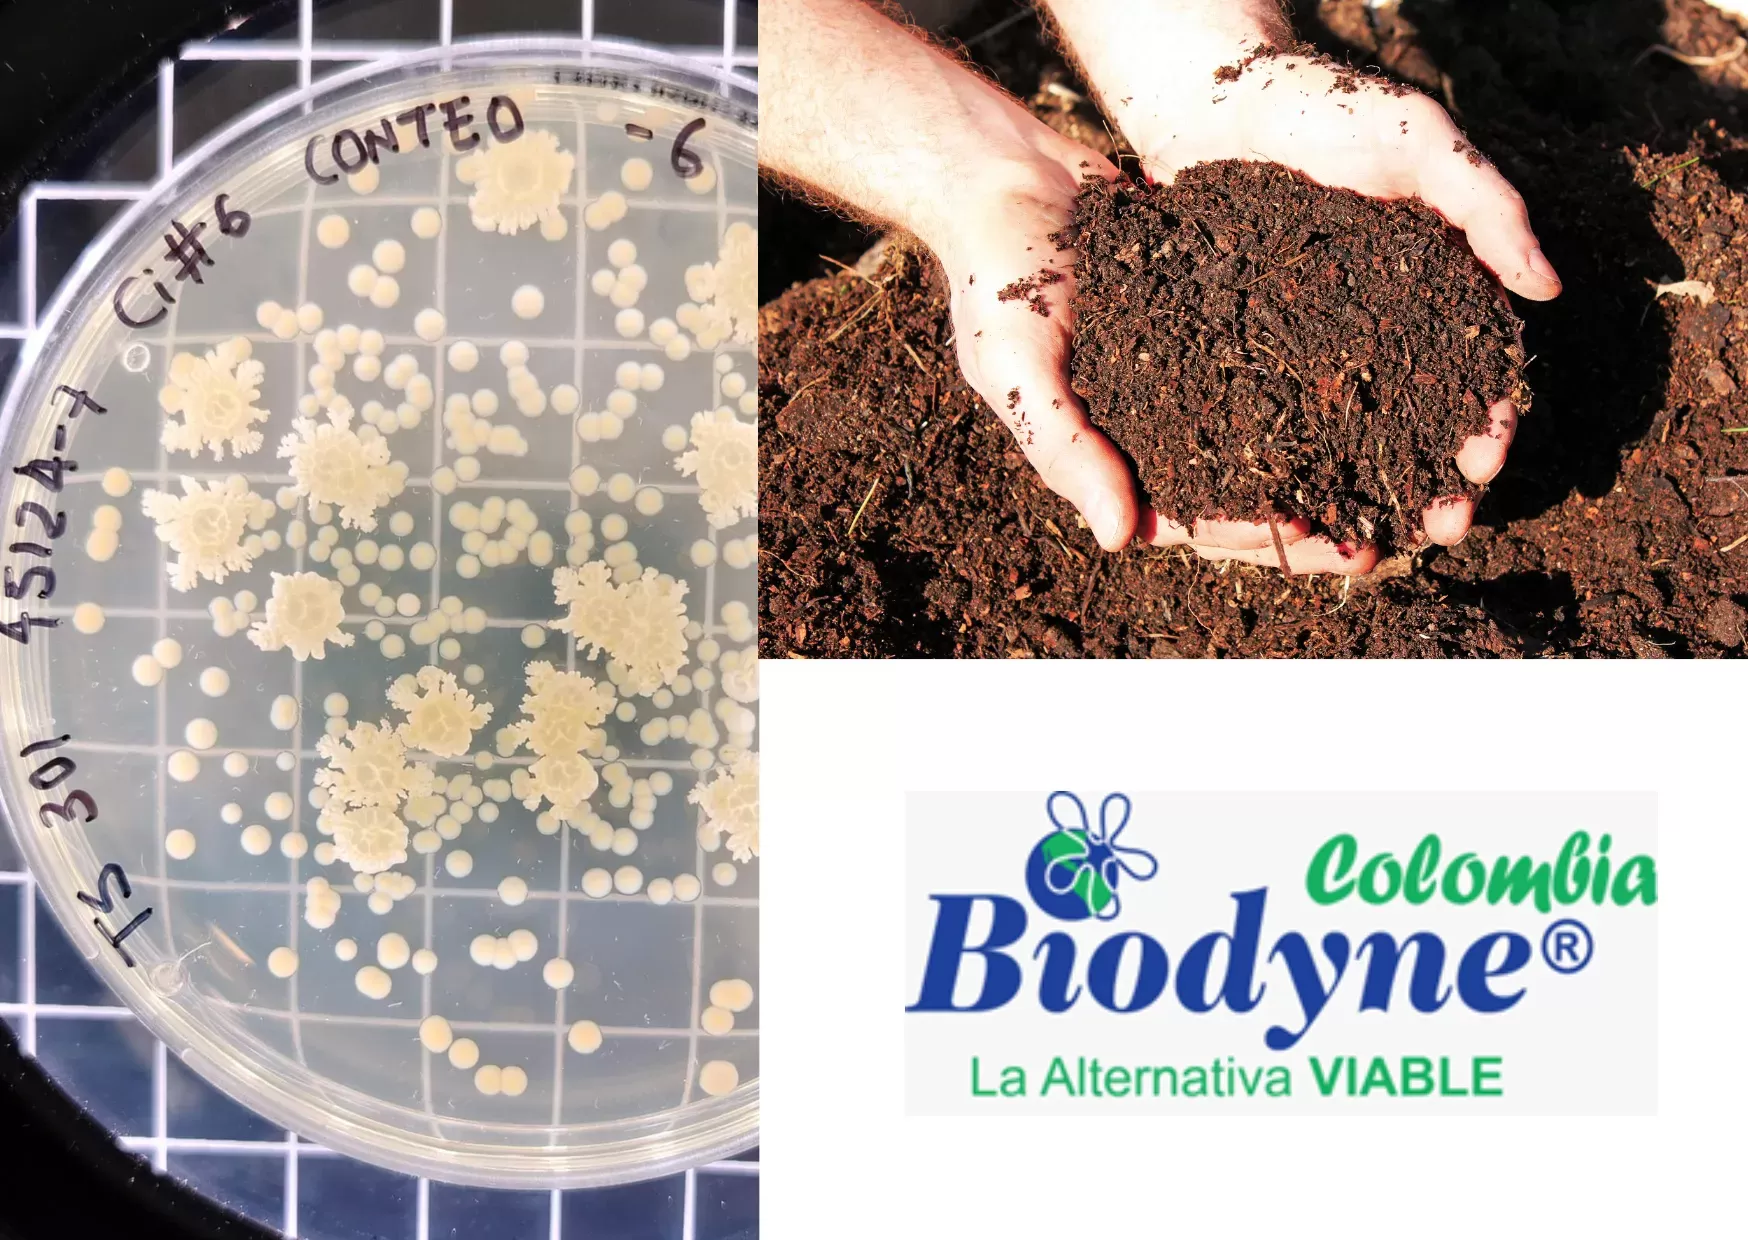

Biodyne® 301 Complex es un poderoso consorcio microbiano formulado para degradar residuos agroindustriales ricos en polímero naturales. El producto contine 30 cepas de bacterias vivas benéficas (algunas facultativas) y hongos que producen proteasas, amilasas, esterasas, lipasas, fosfatasas, ligninasas, celulasas, quitinasas y ureasas.
Biodyne® 301 Complex en la industria:
1. Residuos de Celulosa de la Industria Papelera y Textil:
Restos de pulpa de papel, fibras de algodón, y lino.
2. Residuos de Almidón de la Industria Alimentaria:
Desperdicios de procesamiento de maíz, patata, trigo, y arroz.
3. Residuos de quitina y quitosano de la Industria Pesquera:
Exoesqueletos de crustáceos como cangrejos y camarones.
4. Residuos de queratina de la Industria de la Lana y el Cuero:
Desperdicios de lana y pieles animales.